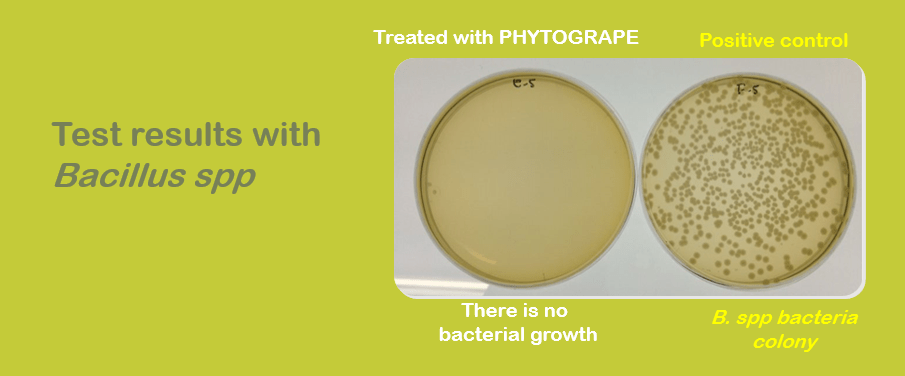
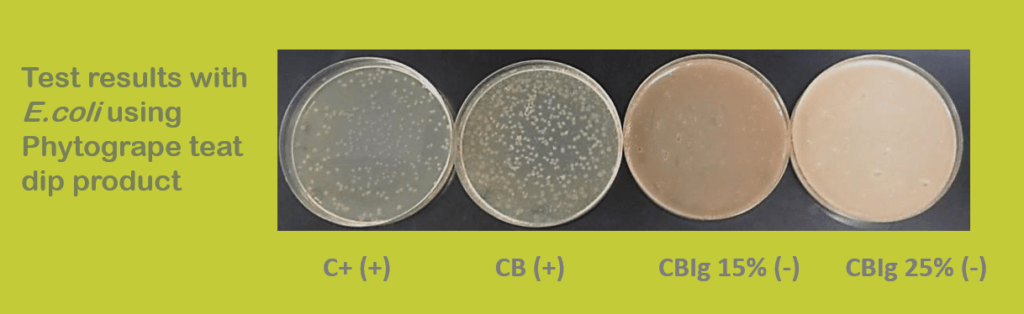

Bacteriological tests

Objetives
To confirm if the antibacterial activity of Phytogrape is effective against Staphylococcus Aureus (Gram + bacteria)
Material and methods
-Growth medium: Luria Broth (LB) medium for bacteria: 1% triptone, 1% NaCl, 0,5%
-Growth conditions: bacteria were grown in LB medium at 37⁰C
-Bracket: placas Petri dish
To confirm if the antibacterial activity of Phytogrape is effective against Bacillus spp (Gram + bacteria)
Objetives
To confirm if the antibacterial activity of Phytogrape is effective against Escherichia Coli (Gram – bacteria)
Material and methods
-Growth medium: Luria Broth (LB) medium for bacteria: 1% triptone, 1% NaCl, 0,5%
-Growth conditions: bacteria were grown in LB medium at 37⁰C
-Bracket: placas Petri

